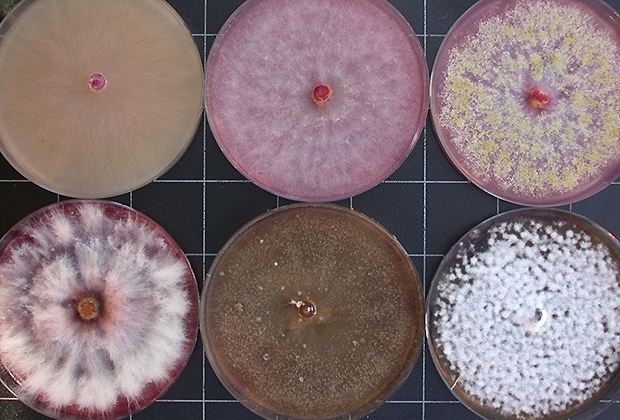

Wissenschaftler der Universität Hohenheim arbeiten derzeit an neuen Verfahren zur Züchtung pilzresistenter Weizensorten. „Wir wollen durch eine Analyse des gesamten Weizengenoms die Regionen für die Resistenz gegen Fusarium dingfest machen“, erklärte Thomas Miedaner vergangene Woche.
Im ersten Schritt sollen laut Miedaner die Bereiche im Weizengenom erkannt werden, die für die Fusarienresistenz verantwortlich sind. Dazu würden rund 1'200 Weizensorten auf ihre Resistenz im Feldversuch untersucht und ihr Genom analysiert. Wenn man dabei Zusammenhänge finde, könnten resistente Pflanzen bereits im Labor anhand ihrer DNS erkannt werden.
In Zukunft könnten mit Hilfe dieser „genomischen Selektion“ effektiver resistente Weizensorten gezüchtet werden, was nicht nur für Lebensmittel wichtig sei, sondern auch den Nutztieren gut tue. Die Herausforderung der Züchtung neuer Weizensorten bestehe darin, so Miedaner, dass diese neben ihrer Fusarienresistenz noch viele andere Kriterien erfüllen müssten, um sich auf dem hart umkämpften Weizenmarkt zu behaupten.
Dazu zählten etwa die Backqualität und eine frühe Reife; ebenso werde Kurzstrohigkeit erwünscht, erläuterte der Wissenschaftler. Insgesamt müsse ein „guter“ Weizen fast 30 Kriterien erfüllen. „In unserem Projekt analysieren wir mit einer neuen chipbasierten Technik das Genom sowohl des Weizens als auch der Fusarien und testen anschließend die Wirkung der gefundenen Gene im Feldversuch“, berichtete Miedaner.
Ziel sei es, durch eine Kreuzung die optimale Kombination von Weizen-Genotypen zu finden und zu verstehen, was die Fusarium-Pilze so gefährlich mache. „Wir möchten möglichst viele positive Eigenschaften des Weizens mit der neuen Methode vereinen“, betonte der Forscher. Die Feldversuche in Hohenheim sollen im kommenden Juni zur Weizenblüte starten. Die größte Schwierigkeit sei, dass die Fusarien aggressiver werden könnten, wenn hoch resistenter Weizen auf grossen Flächen angebaut werde.
Das Bundesforschungsministerium fördert das internationale Projekt laut Hochschulangaben mit rund 1,6 Mio Euro, davon entfallen 362'000 Euro auf die Universität Hohenheim.